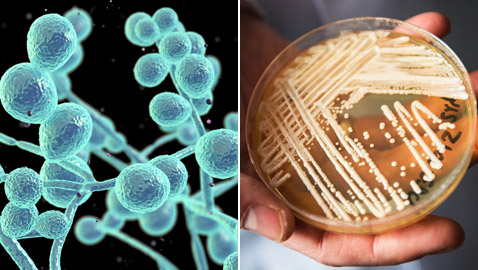
داء فطر البقع البيضاء.. تحذير من بكتيريا نادرة تشكل تهديدا عالميا!

انت في زاوية "عالم المرأة"

مع بلوغ الثلاثين، ربما تجدين بعض للتفاصيل
تمتلك الملكة إليزابيث الثانية، ملكة للتفاصيل
عندما تصبحين حاملاً ستضطرين إلى تغيير للتفاصيل
يقولون: "لغة الجسد أصدق من لغة اللسان"، للتفاصيل
يرغب الكثيرون في تجديد ديكور منازلهم للتفاصيل
تعد "التريفالا" الحل الأمثل، إذا كنتِ للتفاصيل
نسمع في كثير من الأحيان أن الأهل للتفاصيل
أعلن مسؤولو الصحة في ولاية أوريغون للتفاصيل
إنها مناسبة للاحتفال بالسنة الجديدة، للتفاصيل
لا شكّ أنّ هناك بعض الأطعمة التي تمتلك للتفاصيل

السابق
السابق للتواصل معنا
للتواصل معنا 